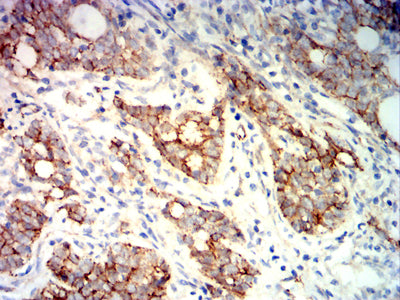

Mouse Monoclonal Antibody to CTNNB1
货号:
31971
别名:
CTNNB; MRD19; armadillo;Beta-catenin
应用:
WB,IHC,FCM
反应种属:
Human, Mouse, Rat, Monkey
抗体类型:
Primary antibody
Swissprot:
P35222
规格:
目录价
在线咨询
Description |
|---|
The protein encoded by this gene is part of a complex of proteins that constitute adherens junctions (AJs). AJs are necessary for the creation and maintenance of epithelial cell layers by regulating cell growth and adhesion between cells. The encoded protein also anchors the actin cytoskeleton and may be responsible for transmitting the contact inhibition signal that causes cells to stop dividing once the epithelial sheet is complete. Finally, this protein binds to the product of the APC gene, which is mutated in adenomatous polyposis of the colon. Mutations in this gene are a cause of colorectal cancer (CRC), pilomatrixoma (PTR), medulloblastoma (MDB), and ovarian cancer. Alternative splicing results in multiple transcript variants. |
References |
|---|
| 1.Anticancer Res. 2016 Apr;36(4):1599-604. 2.Int J Clin Exp Pathol. 2015 Nov 1;8(11):14989-94. |
Specification |
|
|---|---|
| Aliases | CTNNB; MRD19; armadillo;Beta-catenin |
| Entrez GeneID | 1499 |
| Swissprot | P35222 |
| clone | 5B6E9 |
| WB Predicted band size | 85.5kDa |
| Host/Isotype | Mouse IgG1 |
| Antibody Type | Primary antibody |
| Storage | Store at 4°C short term. Aliquot and store at -20°C long term. Avoid freeze/thaw cycles. |
| Species Reactivity | Human, Mouse, Rat, Monkey |
| Immunogen | Purified recombinant fragment of human CTNNB1 (AA: 632-781) expressed in E. Coli. |
| Formulation | Purified antibody in PBS with 0.05% sodium azide |
Application |
|
|---|---|
| WB | 1/500 - 1/2000 |
| IHC | 1/200-1/1000 |
| FCM | 1/200-1/400 |
| ELISA | 1/10000 |
Product Image
-
Black line: Control Antigen (100 ng);Purple line: Antigen (10ng); Blue line: Antigen (50 ng); Red line: Antigen (100 ng)

-
Western blot analysis using CTNNB1 mouse mAb against Hela (1), HepG2 (2),NIH3T3 (3),MCF-7 (4), C6 (5),COS-7 (6),K562 (7),Jurkat (8), A549 (9),SH-SY5Y (10),BEL-7402 (11), HEK293 (12), and HEK293-6e (13) cell lysate.

-
Flow cytometric analysis of HepG2 cells using CTNNB1 mouse mAb (green) and negative control (red).

-
Flow cytometric analysis of A549 cells using CTNNB1 mouse mAb (green) and negative control (red).

-
Immunohistochemical analysis of paraffin-embedded human cervical cancer tissues using CTNNB1 mouse mAb with DAB staining.

-
Immunohistochemical analysis of paraffin-embedded human rectal cancer tissues using CTNNB1 mouse mAb with DAB staining.

鄂公网安备42018502007531号

